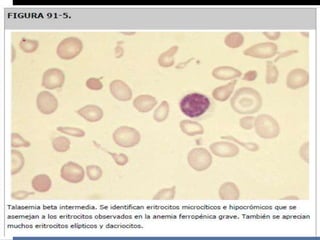

La hemoglobina es vital para transportar oxígeno a los tejidos. Las hemoglobinopatías son trastornos hereditarios que afectan la estructura, función o producción de hemoglobina. Las talasemias son un grupo de anemias hereditarias caracterizadas por una disminución en la síntesis de una o más cadenas de globina, lo que causa hipocromía y microcitosis. La talasemia beta grave causa una anemia severa que requiere transfusiones regulares, mientras que la talasemia beta leve puede causar una anemia leve